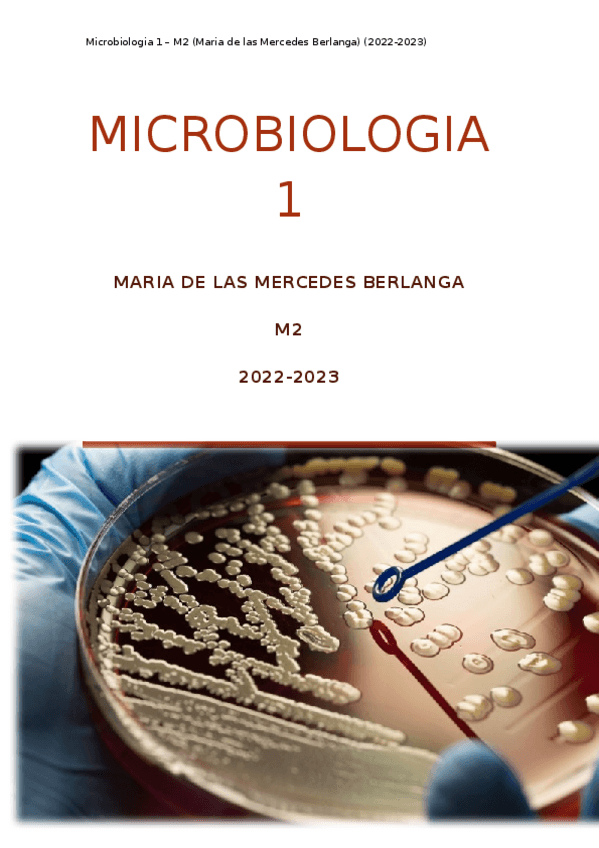

@alejandrommf
16 Publicaciones
329 Interacciones
2 Seguidores
6 Siguiendo
Lista de publicaciones de alejandrommf
He publicado nuevos apuntes de 3º Microbiología II: Toxinas-y-mecanismo-toxigenico.pdf
He publicado nuevos apuntes de 3º Microbiología II: Taula12.Virus-dsDNA3.pdf
He publicado nuevos apuntes de 3º Microbiología II: Taula13.Virus-dsDNA4-Hepeviridae.pdf
He publicado nuevos apuntes de 3º Microbiología II: Taula11.Virus-dsDNA2-Herpesviridae.pdf
He publicado nuevos apuntes de 3º Microbiología II: Taula10.Virus-dsDNA1-Papilloma-Adenoviridae.pdf
He publicado nuevos apuntes de 3º Microbiología II: Taula9.Virus-ssDNA.pdf
He publicado nuevos apuntes de 3º Microbiología II: Taula8.Virus-dsRNA-segmentado.pdf
He publicado nuevos apuntes de 3º Microbiología II: Taula7.Virus-ssRNA--segmentado.pdf
He publicado nuevos apuntes de 3º Microbiología II: Taula6.Virus-ssRNA--2.pdf
He publicado nuevos apuntes de 3º Microbiología II: Taula5.Virus-ssRNA-.pdf
He publicado nuevos apuntes de 3º Microbiología II: Taula4.Retroviridae-ssRNAdiploide.pdf
He publicado nuevos apuntes de 3º Microbiología II: Taula3.Coronaviridae-ssRNA.pdf
He publicado nuevos apuntes de 3º Microbiología II: Taula2.Virus-ssRNA-2.pdf
He publicado nuevos apuntes de 3º Microbiología II: Taula1.Virus-ssRNA.pdf
He publicado nuevos apuntes de 2º Fisiología y Fisiopatología I: Fisiopato-1-TEMARI-SENCER-22/23.pdf
He publicado nuevos apuntes de 2º Microbiología I: Microbiologia-1-TEMARI-SENCER-22/23.docx